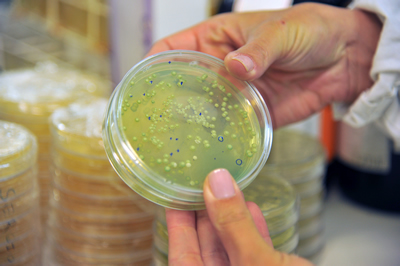

Laboratórios de Serviços Tecnológicos
Área das Ciências Agrárias e Biológicas

Contato
Se sua empresa busca inovação e qualidade e para isso necessita de serviços com credibilidade, de consultoria técnica especializada, ou de uma capacitação técnica específica para seus funcionários, entre em contato conosco.
Coordenadoria de Serviços
Serviços Tecnológicos - Atendimento ao cliente - servicostecnologicos@ucs.br - (54) 3218-2168 - WhatsApp (54) 99980-2168